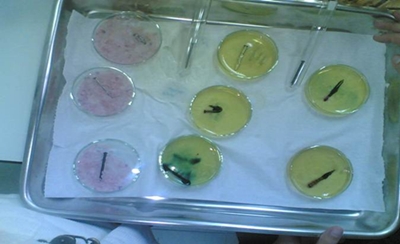

|
Objectivos do Trabalho . Interpretar a necessidade de um rigoroso contacto de variáveis na realização de ensaios de elementos metálicos; . Saber como elaborar tabelas de registo de dados; . Interpretar tabelas dos resultados obtidos; . Identificar os factores que afectam a corrosão de um metal; . Conhecer os diversos tipos de protecção de metais; . Saber se a forma do objecto, presença de outros metais, ou o pH afectam ou não a corrosão de um metal e a sua rapidez; . Aumentar a prática no manuseamento do material laboratorial, principalmente no uso do microscópio. Introdução Teórica Os metais constituem cerca de ¾ dos elementos existentes na Terra. Geralmente não se encontram no estado puro, mas sim combinados com outros elementos. Uma vez purificados, todos os metais apresentam características comuns: em condições normais são sólidos, excepto o mercúrio, que é líquido; são dúcteis, maleáveis, as suas superfícies são brilhantes e reflectem a luz. Os metais sempre desempenharam um papel muito importante no desenvolvimento e sustentabilidade do homem. Quanto maior a perícia no desenvolvimento de metais, mais forte o homem se tornava. Desde que o homem começou a utilizar os metais até aos nossos dias, estes nunca foram dispensáveis, utilizados em quase todo o tipo de construções e ainda na construção de artilharia militar. Ao longo do tempo o homem começou a constatar que os metais, elementos de grande utilidade e que se degradavam com o passar do tempo. Assumiam uma coloração diferente e formavam uma camada de detritos. Todos estes factores são derivados da corrosão dos metais. A corrosão metálica é a transformação de um material metálico ou liga metálica pela sua interacção química ou electroquímica num determinado meio de exposição, processo que resulta na formação de produtos de corrosão e na libertação de energia. Geralmente, a corrosão metálica (por mecanismo electroquímico), está associada à exposição do metal num meio no qual existe a presença de moléculas de água, juntamente com o gás oxigénio ou íões de hidrogénio, num meio condutor. A corrosão dos metais sempre foi um problema muito difícil de resolver, pois por mais que o metal esteja protegido, com o passar do tempo a protecção deteriora-se e o meio ambiente encarrega-se de corroer o metal. A adição de uma ou mais formas de protecção contra a corrosão dos metais deve levar em conta aspectos técnicos e económicos. Entre os aspectos técnicos, o meio de exposição é um parâmetro de grande importância. Estes avanços irão aumentar a durabilidade dos metais. Em suma, são muitos os casos em que os metais ferrosos continuam a ser os materiais mais adequados para utilização em estruturas expostas a atmosferas em geral, restando tão-somente a interposição de uma barreira entre este metal e o meio como uma forma de protecção contra a corrosão. Para esta finalidade, tanto os revestimentos orgânicos (tintas), como os inorgânicos (revestimentos metálicos ou de conversão como a anodização, cromatização) ou uma combinação dos dois são utilizados. A escolha de um sistema de protecção contra a corrosão para os metais ferrosos dependerá de uma série de factores, citando como um dos principais, o grau de corrosibilidade do meio. Com esta experiência pretende-se saber os factores que afectam a corrosão dos metais, estudando o comportamento de peças metálicas de formas variadas, protegidas com ou sem outros metais e sujeitas a diversas condições. Material e Reagentes
Procedimento Experimental 1. Preparou-se um conjunto de amostras de pregos de ferro e de aço em diferentes condições: a) Pregos intactos; b) Pregos dobrados; c) Pregos com risco à superfície; d) Pregos pintados, com e sem riscos na pintura; e) Pregos enrolados em fio de cobre e papel de alumínio.
Fig.1- Pregos intactos
Fig.2- Prego pintado
Fig.3/4- Pregos riscados
Fig.5- Prego dobrado 2. Preparou-se um conjunto de meios distintos: a) Água destilada; b) Água fervida (ausência de oxigénio dissolvido); c) Água do mar (ou solução de NaCl equivalente); d) Solução acida (por exemplo vinagre); e) Solução básica (por exemplo sonasol verde); f) Óleo alimentar ou parafina líquida (meio hidrófobo não oxigenado); g) Caixa contendo sílica (ou sacos de sílica utilizados no acontecimento de equipamentos sensíveis à humidade); h) Gel de agar-agar, preparado por dissolução de 1,5g de agar-agar em 100ml de água acabada de ferver, adicionando fenolftaleína e o hexacianoferreto(III) de potássio e esperar o tempo que arrefeça e solidifique. 3. Mergulharam-se as amostras de ferro anteriormente preparadas nos meios escolhidos e guardar 4. Construiu-se uma tabela de resultados esperados. 5. Observaram-se as peças semanalmente e registou-se a evolução das características superficiais. Resultados Obtidos
Legenda:
Fig.6- Prego em contacto com o ar
Fig.7- Prego A1
Fig.8- Prego A1d
Fig.9- Prego A1r
Fig.10- Prego A1c
Fig.11- Prego A1a
Fig.12- Prego B1
Fig.13- Prego B1r
Fig.14- Prego B2
Fig.15- Prego B2r
Fig.16- Prego B3
Fig.17- Prego A3c
Fig.18- Prego A3a
Fig.19- Prego A6
Fig.20- Prego A8
Fig.21- todas as amostras com pregos em sílica e gel de agar-agar Discussão dos Resultados Após uma análise atenta dos resultados obtidos, chegamos à conclusão que os principais agentes responsáveis pela formação de ferrugem são a água e o oxigénio. No entanto existem vários métodos de proteger os metais contra a corrosão, e de entre os quais se destacam: camada protectora, como a pintura ou plastificação; protecção anódica; galvanização; protecção catódica. Um dos factores que pode também influenciar a corrosão dos metais é a temperatura, uma vez que o seu aumento faz aumentar também o nível de oxidação do metal. O oxigénio, a água e os iões que a incluem são indispensáveis para iniciar a corrosão na superfície de um metal. Pregos em água destilada, fervida e salgada apresentam corrosão e depósito de ferrugem. Em princípio na água fervida não devia existir oxidação, pois ao ferver a água, o oxigénio diluído nela diminui, retardando o efeito da corrosão. No espaço de tempo em que a experiência esteve de repouso, não teria tempo de oxidar como aconteceu na experiência. Provavelmente quando a água arrefeceu, incorporou na sua constituição oxigénio, comportando-se como a água destilada. Em relação ao prego riscado este oxidou, na presença de ar, água destilada, água fervida, NaCl, e Agar-agar. Esta oxidação deve-se ao facto de ao se riscar o prego, danificou-se a sua superfície facilitando também a oxidação. Estes resultados encontram-se em parte de acordo com os resultados esperados. O mais estranho é que os pregos intactos e os pregos dobrados não oxidaram na solução ácida, não apresentando ferrugem, nem depósito. Já os pregos riscados apresentavam uma corrosão muito acentuada mesmo na solução básica, um meio onde o metal tem dificuldade em ceder electrões, pois os metais são mais atacados nas irregularidades. Verificou-se que nada oxida na perafina, visto que esta não contem água, (indispensável para a formação da pilha que instantaneamente iria corroer os pregos). Podemos observar e concluir através da realização da experiência, que a sílica desempenhou um papel importante, uma vez que todos os pregos em contacto com esta não se oxidaram, tal como previsto, dado que esta absorve a humidade impedindo a corrosão. Nos resultados obtidos afirma-se que em todas as amostras no meio do gel agar-agar não ouve oxidação, mas o gel adquiriu a cor rosa o que indica que foi reduzido, logo o ferro teria de ser oxidado, mas não se vê nada azul. Os pregos de aço foram mais afectados que os pregos de ferro, ou seja, este aço tem um poder redutor maior que o do ferro, logo consegue ceder electrões com mais facilidade que o ferro. Por isso irá oxidar com maior velocidade. Os pregos enrolados em fio de cobre estão corroídos na parte não protegida pelo cobre, pois o cobre é um redutor mais fraco que o ferro e o aço, deixando que eles oxidem. Nos pregos em papel de alumínio, estes não oxidam, porque o alumínio é um redutor mais forte que o ferro e o aço, servido de ânodo de sacrifício. Não foi possível elaborar a experiência com pregos pintados, devido a um pequeno incidente, nem com pregos de aço dobrados, porque estes partiam no momento da dobra. Conclusão Após a realização da actividade experimental, chegamos à conclusão que bem elaborada. Não conseguimos responder concretamente a alguns resultados obtidos, nem esses mesmos resultados eram os esperados. Após a realização desta actividade experimental, concluímos essencialmente que: O oxigénio e a água são os principais agentes corrosivos do ferro, a corrosão dos metais é uma reacção redox, O ferro na presença de cobre sofre oxidação ( uma vez que o seu potencial normal de redução é menor do que o potencial normal de redução do cobre), A temperatura também influencia o nível de oxidação, O ferro é mais sujeito á corrosão do que o aço, uma vez que o aço é constituído por ferro e carbono, Nenhum dos pregos em contacto com a sílica sofreu oxidação, uma vez que esta absorve a humidade, Os factores que afectam a corrosão são: materiais em contacto com o ferro; condições ambientais, tais como a temperatura, o nível de oxigénio, o ar, etc.; e que existem metais que protegem outros metais de serem corroídos, devido ao poder redutor superior. Bibliografia DANTAS, M. , RAMALHO, M., Jogo de Partículas, Texto Editores, 2005. DANTAS, M. , RAMALHO, M., Jogo de Partículas, Texto Editores, 2004. Http://pt.wikipedia.org/w/index.php? Title=Cobre&action=9 http://www.rioboatshow.com.br/rbs/rbs2005/paragon/corrosaode mis.doc http://www.notapositiva.com Outros Trabalhos Relacionados
|
|